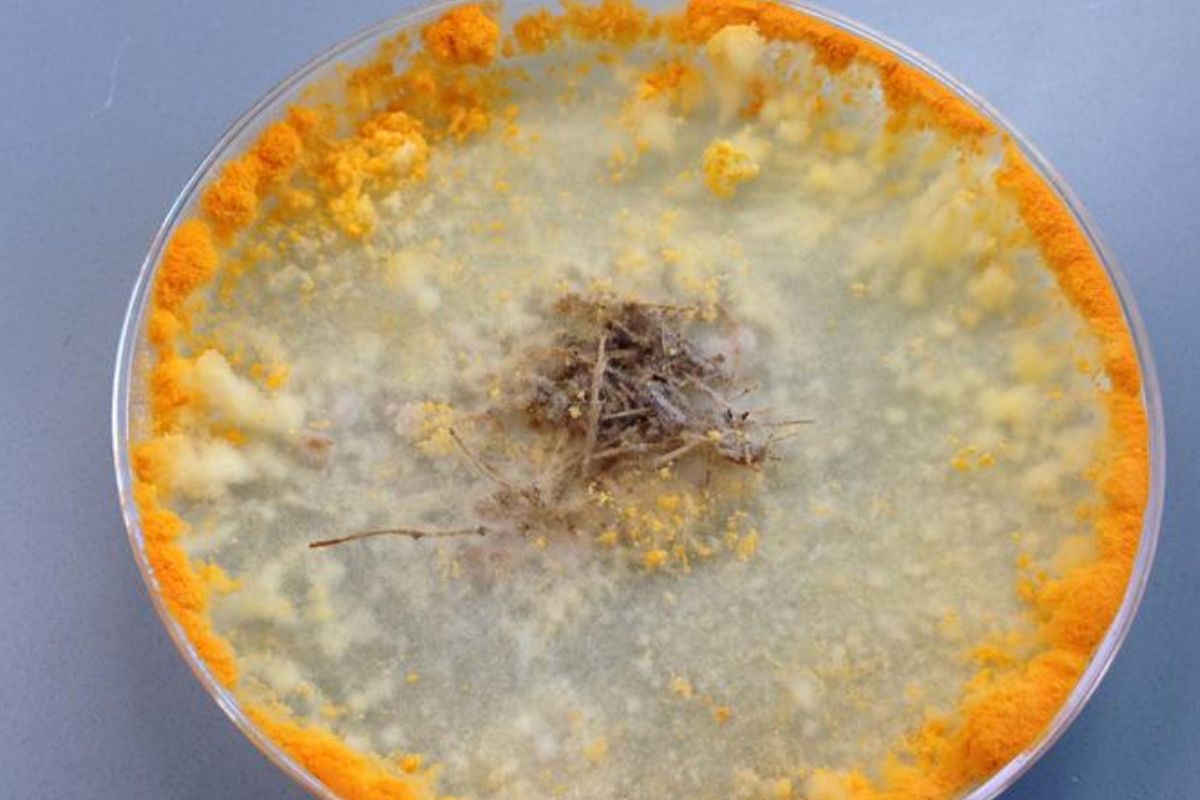

Des ingénieurs inventent un béton capable de se réparer tout seul.
Le ciment artificiel a été inventé en 1817 par Louis Vicat, un ingénieur français, lors de la construction d’un pont sur la Dordogne. Il a découvert les principes d’hydraulicité des liants, c’est-à-dire la capacité du ciment à durcir sous l’eau, en combinant calcaire et argile. Depuis son invention a fait du chemin mais si la façon de le produire a bien évolué depuis le XIXe siècle, il est une chose qui n’a que peu changé : la pollution engendrée.
Des chercheurs américains vont peut être changé cet état de fait après avoir mis au point un “béton vivant”, associant bactéries et champignons, qui aurait l’incroyable capacité de se régénérer !
Et ce, grâce à une moisissure qu’on trouve normalement… sur du pain pourri.
Lire aussi :
- Le béton des centrales nucléaires a une propriété exceptionnelle sous l’effet des radiations : il est capable de s’auto-régénérer
- Ce projet titanesque va remettre l’Europe au centre du monde de la construction avec un tunnel pour relier l’Afrique au vieux continent
Un béton “auto-réparant” ? C’est l’incroyable invention d’une université américaine qui promet de secouer le secteur de la construction
Contrairement aux matériaux bio classiques qui se dégradent rapidement, l’invention de l’université d’État du Montana reste fonctionnelle plus d’un mois, un record pour ce type de structure vivante. Ce gain de durabilité ouvre enfin la porte à des applications concrètes : réparation automatique, dépollution, et résilience architecturale.
Un champignon bien connu au cœur du procédé
Le cœur du système repose sur le mycélium de Neurospora crassa, une espèce fongique aussi connue sous le nom de “moisissure du pain orange”. Les scientifiques ont utilisé ce réseau de filaments comme échafaudage biologique, autour duquel se développe le matériau.
Le mycélium permet de créer des structures internes complexes, presque organiques, qui rappellent l’os cortical dans leur géométrie. Une propriété idéale pour concevoir des matériaux aussi résistants qu’adaptables.
L’ensemble est ensuite minéralisé par des bactéries, qui créent une sorte de ciment naturel. Le résultat est un matériau léger, modulaire, partiellement vivant, et surtout : capable de s’auto-réparer.
Un potentiel architectural insoupçonné
L’équipe a réussi à créer des formes internes sur mesure, capables de répondre aux défis de l’ingénierie moderne. À terme, on pourrait imaginer des murs porteurs, des dalles ou même des éléments de design façonnés à partir de champignons… et résistants à l’usure.
Ce matériau réagit à son environnement, répare ses microfissures, et pourrait décomposer certains polluants dans les zones urbaines.
Autrement dit, il ne se contente pas d’exister : il travaille en silence pour prolonger sa propre vie utile, tout en améliorant l’impact écologique du bâtiment.
Une alternative au ciment qui étouffe la planète
La pollution du secteur de la construction est une source majeure d’émissions de gaz à effet de serre, représentant environ 37 % des émissions mondiales liées à l’énergie en 2022. Elle résulte principalement de la consommation énergétique des bâtiments, des matériaux de construction comme le ciment, l’acier et l’aluminium, ainsi que des processus de fabrication et de transport. En France, le secteur du bâtiment génère environ 23 % des émissions nationales, notamment à cause de la construction neuve et de l’utilisation intensive de matériaux à forte empreinte carbone.
Le ciment représente à lui seul près de 8 % des émissions mondiales de CO₂. Il est partout : dans nos routes, nos écoles, nos maisons. Et sa fabrication reste énergivore, polluante, difficile à verdir.
Ce béton vivant, produit à basse température, pourrait offrir une solution partielle. Même s’il ne remplacera pas le béton classique dans toutes les situations, il pourrait réduire la dépendance aux matériaux les plus carbonés, notamment dans les constructions légères ou modulaires.
C’est un premier pas vers une architecture régénérative, où le bâtiment ne se contente pas de “ne pas nuire”, mais devient un organisme actif dans son écosystème.
Une invention à l’épreuve de l’industrialisation
Pour l’instant, le béton fongique n’en est qu’au stade de prototype en laboratoire. Les chercheurs veulent maintenant :
- prolonger la durée de vie des cellules vivantes,
- renforcer la résistance mécanique,
- et développer des méthodes de production à grande échelle.
Le défi est double : garder les cellules vivantes assez longtemps, tout en garantissant que le matériau reste stable, durable, et fonctionnel sur un chantier.
Mais la voie est ouverte. Et avec les progrès rapides des biotechnologies, il ne serait pas surprenant de voir, d’ici quelques années, des bâtiments vivants sortir de terre, capables de s’adapter, de s’auto-entretenir et même de dialoguer avec leur environnement.
Source : https://doi.org/10.1016/j.xcrp.2025.102517




Les Romains n’ont pas attendu les Américains pour inventer le béton auto réparant.
Rendons à César ce qui est à César…